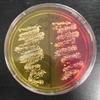

| ||||
Science Image Library
Bacterial Growth Media
from Science Prof Online
1, 2 & 3. Liquid Tryptic Soy Agar TSY with bacterial growth (floculate);
4 & 5. Sterile liquid growth medium.
1. Slant tube of TSY agar growing Staphylococcus epidermidis; 2. 3. & 4. Slant tubes with various solid media and bacterial growth; 5. Slant tube of Enterococcus bacteria.
1. Plate of sterile Blood Agar.
2. Beta hemolysis from throat swab sample plated on Blood agar = Streptococcus pyogenes.
3 & 4. Alpha-hemolysis on Blood Agar, viewed from top of plate (3) and underside (4).
5. What gamma-hemolysis would look like viewed from underside of plate.
1. Sterile Mannitol Salt Agar.
2. MSAr plates with bacterial growth. Mannitol+ pathogen left, Mannitol- normal flora right.
3. S. epi written in mannitol negative Staphylococcus epidermidis and growing on MSA.
4. Mannitol Salt Agar viewed from top. Yellow side of plate growing mannitol+ pathogen Staph aureus. Pink side of plate growing mannitol- normal flora Staph epidermidis.
5. Mannitol-negative Staph epi growing in punctiform colonies on MSA.
Slant Tubes of Various Solid Media (Click on image to enlarge.)
Mannitol Salt Agar (MSA) (Click on photo to enlarge. See more)
MacConkey's Agar (MAC) (Click on image to enlarge. See more)
Liquid Bacterial Growth Medium (Click on image to enlarge.)
Blood Agar (BAP) Photos (Click on image to enlarge. See more)
Science Image Library: Bacterial Growth Media
1.Sterile MacConkey's Agar.
2. MacConkey's Agar growing Gram-negative bacteria. Left plate growing lactose-negative Salmonella, right plate growing lactose-positive E. coli.
3. "Ecoli" written on MAC using Lac+ E. coli bacteria.
4. Pink, lac+ colony growing on MAC.
5. Smiley face of lac+, Gram- bacteria growing on MAC.
TSY Bacterial Growth Medium (Click on image to enlarge.)
1. Arm plate of TSY growing normal flora colonies of bacteria; 2. Warm sterile TSY as liquid in bottle; 3. Plate of TSY agar and inuculation loop;
4. Plate of TSY agar & swab; 5. Antibiotic zones of inhibition on TSY agar growing Staphylococcus.
Page last updated: 2/2016
SCIENCE PHOTOS
Aseptic Technique for Pouring Agar (Click image to enlarge.)
1. Obtain sterile agar from warming oven.
2. Remove cap and hold it, opening pointed down to avoid contamination.
3. Flame neck of bottle.
4. Pour 1/4" of agar into bottom of Petri plate. Only open lid as far as necessary.
5. Flame neck of bottle, replace cap, and return bottle to warming oven.
1. Blood agar. What type of hemolysis pattern?; 2 & 3. Specialized media #1 is MacConkey's; Specialized media #2 is Mannitol Salt
Specialized Growth Media Streaked with Unknown Bacteria: Photos for Testing Students
(Click on image to enlarge. See more)
Didn't find what you need?
Search SPO for a Photo
MacConkey's Agar (MAC) Specialized
Bacterial Growth Medium
Blood Agar (BAP) Specialized
Bacterial Growth Medium
Mannitol Salt Agar (MSA) Specialized
Bacterial Growth Medium
SPO VIRTUAL CLASSROOMS
 | ||||||
SCIENCE VIDEOS
The Microbiology Image Library is the largest photo collection on the SPO site. To help you more easily find what you're looking for, select the "See more" link of the sub-topic below that corresponds to your interests or use the search boxes to search our site.
The SPO Science Image Library is a continuously growing collection of free science photographs. If you use one of our free, low-res images, we just ask that you give us credit and provide a link to the SPO website (scienceprofonline.com). Click on an image to enlarge it. To save a photo to your computer, right click on it and select "Save".
For those in need of high-resolution images, we will soon be offering hi-res files of many photos in the Science Image Library. Follow us on Twitter @ScienceProfSPO to get updates on new SPO features and products. If you need a high resolution photo now, please contact us.
You have free access to a large collection of materials used in a college-level introductory microbiology course. The Virtual Microbiology Classroom provides a wide range of free educational resources including PowerPoint Lectures, Study Guides, Review Questions and Practice Test Questions.
More Bacterial Growth Media & Cultures Resources
- Comparison of Liquid & Solid Bacterial Growth Media "class notes"article from Science Prof Online.
- Aseptic Technique to Pour Bacterial Growth Media Into Petri Dishes "class notes"article.
- Differential & Selective Bacterial Growth Media "class notes" article.
- Types of Culture Media for Growing Bacteria "class notes" article.
TV show, from Animal Planet, presenting case studies of people with parasitic infections. So interesting, you'll learn about parasitism without even trying!
Check out our FREE
Monsters Inside Me
Homework Assignments
 | ||||
The VMC offers homework assignments based on Radiolab podcasts.
RADIOLAB PODCASTS:
HOMEWORK ASSIGNMENTS: